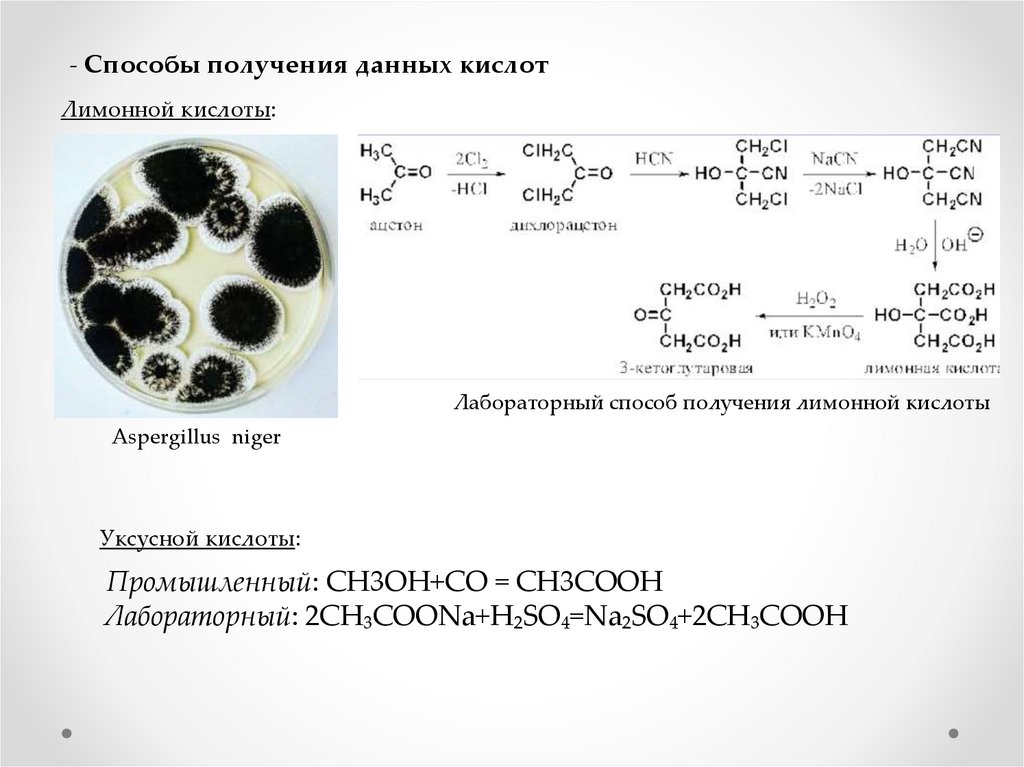

Похожие презентации:
Лимонная и уксусная кислоты на кухне
1.
Департамент образования и науки города МосквыГосударственное бюджетное образовательное учреждение
Города Москвы «Школа №1530»Школа Ломоносова»
ЛИМОННАЯ И УКСУСНАЯ КИСЛОТЫ
НА КУХНЕ
Работа учащейся 9 «З» класса
Александры Лупповой
Руководитель:
Учитель химии Е.О. Фроловская
Москва, 2021
2.
План работы:Актуальность
Цель
Задачи
Объекты исследования
ТЕОРЕТИЧЕСКАЯ ЧАСТЬ
- История открытия лимонной и уксусной кислот
- Основные физические свойства рассматриваемых кислот
- Основные химические свойства рассматриваемых кислот
- Способы получения данных кислот
- Применение данных кислот в жизни людей
ЭКСПЕРИМЕНТАЛЬНАЯ ЧАСТЬ
Эксперимент 1: «Растворение накипи в растворе лимонной кислоты»
Эксперимент 2: «Гашение соды уксусной кислотой»
Эксперимент 3: «Удаление клея от этикеток уксусной кислотой»
Эксперимент 4: «Удаление жира при помощи лимонной кислоты»
- ЗАКЛЮЧЕНИЕ
- Список использованных источников
3.
Актуальность:В нашем мире такие кислоты, как уксусная и лимонная, имеют широкое
применение как в промышленности, так и в быту. Множество проблем решаются
применением этих кислот. Мне стало интересно, почему обсуждаемые объекты
стали незаменимыми помощниками на кухне.
Цель работы:
- Предложить простые и практичные способы использования уксусной и
лимонной кислот.
Задачи работы:
Теоретические:
- Изучить:
1. Историю возникновения лимонной и уксусной кислот;
2. Физические и химические свойства данных кислот;
3. Способы получения лимонной и уксусной кислот;
4. Применение данных кислот.
Практические:
- Провести опыты по выявлению полезных свойств кислот;
- Опытным путём разработать рецепты разрыхлителя, а также удаления накипи,
жира, клея.
Объекты исследования: лимонная кислота(кристаллическое в-во) «HAAS»,
уксусная кислота «Красная цена» 9%-ая.
4.
ТЕОРЕТИЧЕСКАЯ ЧАСТЬ- История открытия уксусной и лимонной кислот
Шведский химик-фармацевт
Карл Вильгельм Шееле
Греческий учёный и
философ Теофраст
Арабский алхимик
Джабир Ибн Хайян
5.
- Основные физические свойства рассматриваемых кислотЛимонная кислота
(HOOCCH2)2C(OH)COOH
(3-гидрокси-3-карбоксипеннтандиовая
кислота)
Уксусная кислота CH3COOH
(этановая кислота)
6.
- Основные химические свойства рассматриваемых кислотСвойства/Кислоты
Лимонная
Уксусная
Основность
Трёхосновная
Одноосновная
Качественная
реакция
Na3C6H5O7 + CaCl2 =
Ca3(C6H5O7)2 + NaCl
3CH3COOH+FeCl3 =
3Fe(CH3COO)+3HCl(при
взаимодействии раствор
окрашивается в тёмнобурый цвет)
Особенности
Проявляет свойства
многоосновных
карбоновых кислот.
Дисоциирует(распадается
в водном растворе) на
лимонную кислоту и
водород.
7.
- Способы получения данных кислотЛимонной кислоты:
Лабораторный способ получения лимонной кислоты
Aspergillus niger
Уксусной кислоты:
Промышленный: CH3OH+CO = CH3COOH
Лабораторный: 2CH₃COONa+H₂SO₄=Na₂SO₄+2CH₃COOH
8.
- Применение данных кислот в жизниЛимонная кислота
Уксусная кислота
9.
ПРАКТИЧЕСКАЯ ЧАСТЬ- Практическая часть
Эксперимент 1 «Растворение накипи в лимонной кислоте»
Материалы и оборудование: кристаллическая лимонная кислота «HAAS», водопроводная
вода, столовая ложка с накипью, огонь.
Химическое уравнение:
(HOOCCH2)2C(OH)COOH + CaCO3=Ca3(C6H5O7)2 + CO2 + H2O
10.
Эксперимент 2: «Гашение соды уксусной кислотой»Материалы и оборудование: уксусная кислота «Красная Цена» 9%-ая,
питьевая сода, маленькая плошка.
Химическое уравнение:
CH₃COOH + NaHCO₃ = CH₃COONa + CO₂ + H₂O
11.
Эксперимент 3: «Удаление клея от этикеток уксусной кислотой»Материалы и оборудование: пластиковая крышка с этикеткой,
уксусная кислота «Красная цена» 9%-ая, сухая тканевая салфетка.
Наблюдение: Уксусная кислота разрушает казеиновый клей.
12.
Эксперимент 4: «Удаление жира при помощи лимонной кислоты»Материалы и оборудование: твёрдая поверхность с жировым
пятном, лимонная кислота «HAAS», горчица(порошок), тряпка, вода
из-под крана.
Наблюдение: Лимонная кислота расщепляет животный жир.
13.
ЗАКЛЮЧЕНИЕТеоретическое исследование:
Изучены:
1. Истории открытия и способы получения лимонной и
уксусной кислот
2. Физические и химические свойства лимонной и уксусной
кислоты и области их применения
Практическое исследование:
1. На основе лимонной кислоты предложено средство для
удаления накипи
2. Получен разрыхлитель на основе уксусной кислоты и
соды
3. На основе уксусной кислоты предложено средство для
удаления казеинового клея
4. На основе лимонной кислоты предложено средство для
удаления жира с твёрдых поверхностей
14.
- СПИСОК ИСПОЬЗОВАННЫХ ИСТОЧНИКОВwww.wikipedia.org
www.acetyl.ru
www.educationspb.ru
www.samlib.ru
Большая Советская Энциклопедия, том 3, третье изд., 1969-1978 гг.
www.newchemistry.ru
www.newchemistry.ru
www.pavlovolimon.ru
Кнунянц И.Л. Химическая Энциклопедия в 5-ти томах, том 2,
изд. «Советская Энциклопедия», 1988 г.
VIDAL.ru
www.hozsektor.ru
ingridienty-ravitie.ru
www.zen.yandex.ru
Рудзитис Г.Е., Фельдман Ф.Г. Химия 9 класс/учебник, изд. «Просвещение»,
2019.
www.nur.kz
www.yandex.ru/images

Кулинария
Кулинария








